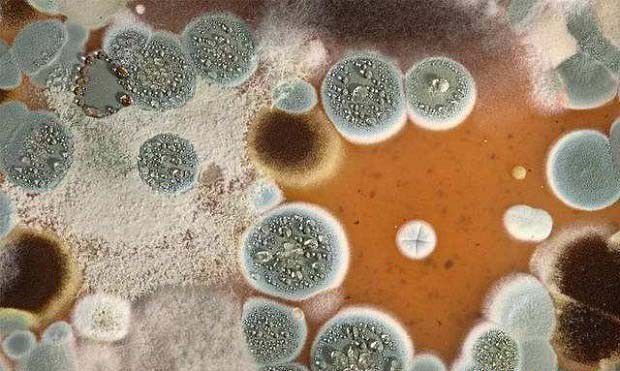
种植灵芝如何防治根霉？

种植灵芝如何防治根霉?
时间:2024-06-17 04:35:28
来源:网络
浏览:3051次
根霉,又称黑色面包霉,是一种常见的侵害灵芝的杂菌,主要是黑根霉。近期有种植灵芝的网友咨询:根霉对灵芝生产有哪些危害,根霉主要有哪些特征?灵芝根霉发生原因是什么,种植灵芝如何预防根霉的发生?栽培灵芝发生根霉后怎么办?以下想种菜网就作简单介绍,供网友们参考。

根霉对灵芝的危害
菌种扩繁及袋栽时常易发生。培养料上感染根霉后,形成网状菌丝体,并产生黑色点状分生孢子,与灵芝竞争养料,造成减产。

灵芝根霉发生原因
根霉广泛分布于土壤、空气、粪便及有机物上,由空气及培养料带菌传播。该菌适应性强,喜中温、高湿、偏酸和碳水化合物含量丰富的环境。一旦感染,料层局部变黑。
防治灵芝根霉措施:
1、培养料要求新鲜、干燥。灭菌要彻底,以杀灭培养料中根霉孢子。
2、接种时,接种环境要认真消毒,防止接种工具沾上生水。
3、培养菌种期间,加强通风换气,保持培养室内干燥和环境卫生清洁,破坏病菌的生存环境。
4、出现根霉侵染后,及时将培养料挖出,混入新鲜培养料中,经灭菌后再利用。
以上就是想种菜网对灵芝的介绍,如您有更好的补充请在下方留言告诉我们。
